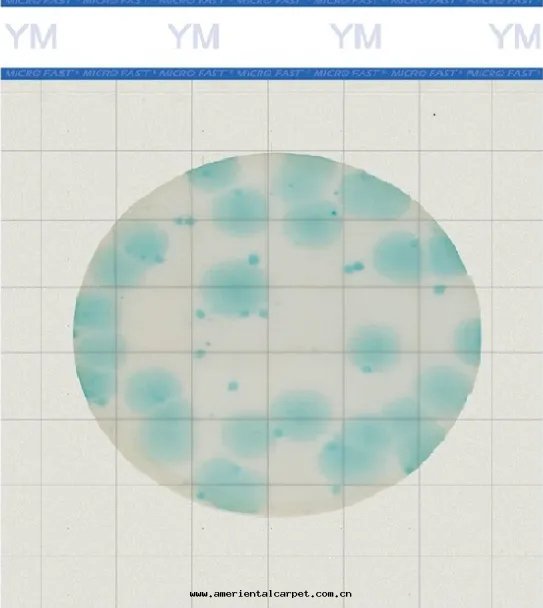
640_副本(běn).jpg

美(měi)正(zhèng)生(shēng)物(wù)牽头(tóu)的(de)《食品中(zhōng)黴菌和(hé)酵母快(kuài)速檢測 測试片(piàn)法》团(tuán)體(tǐ)标(biāo)準立項!
2025-02-27 10:29浏览量(liàng):320
2025 年(nián) 2 月(yuè) 24 日(rì),中(zhōng)國(guó)出(chū)入(rù)境檢验檢疫協会(huì)批準了《食品中(zhōng)黴菌和(hé)酵母快(kuài)速檢測 測试片(piàn)法》团(tuán)體(tǐ)标(biāo)準立項,該标(biāo)準由(yóu)山(shān)東(dōng)美(měi)正(zhèng)生(shēng)物(wù)科技有限公(gōng)司牽头(tóu)起(qǐ)草(cǎo)。
本(běn)标(biāo)準将基于(yú)測试片(piàn)技术,建立适用(yòng)于(yú)不(bù)同(tóng)類(lèi)型食品中(zhōng)黴菌和(hé)酵母快(kuài)速檢測的(de)方(fāng)法體(tǐ)系(xì),針(zhēn)对(duì)常規食品样品和(hé)具有挑戰性(xìng)的(de)样品(牛油(yóu)果(guǒ)、蝦等),制定(dìng)詳细(xì)的(de)操作(zuò)流程和(hé)验收(shōu)指南(nán)。
这(zhè)一(yī)舉措彰顯了美(měi)正(zhèng)生(shēng)物(wù)在(zài)微生(shēng)物(wù)檢測领域的(de)深厚技术積累和(hé)行業引领地(dì)位(wèi)。
美(měi)正(zhèng)生(shēng)物(wù)推出(chū)的(de)MicroFast®Premium系(xì)列黴菌酵母測试片(piàn)法是(shì)用(yòng)一(yī)種(zhǒng)預先制備的(de)含有指示劑及冷(lěng)水(shuǐ)可(kě)溶性(xìng)凝胶(jiāo)的(de)培養基系(xì)統進(jìn)行微生(shēng)物(wù)培養的(de)方(fāng)法。培養基中(zhōng)含有黴菌和(hé)酵母生(shēng)长(cháng)的(de)主(zhǔ)要(yào)营養物(wù)質(zhì)和(hé)功能(néng)性(xìng)物(wù)質(zhì)(如顯色(sè)底物(wù)、冷(lěng)水(shuǐ)可(kě)凝胶(jiāo)等)。
黴菌和(hé)酵母生(shēng)长(cháng)过(guò)程中(zhōng)代(dài)謝产生(shēng)的(de)酶與(yǔ)測试片(piàn)中(zhōng)的(de)顯色(sè)底物(wù)發(fà)生(shēng)反(fǎn)應(yìng),釋放(fàng)顯色(sè)基团(tuán),累積後(hòu)信(xìn)号(hào)放(fàng)大(dà),在(zài)可(kě)見(jiàn)光(guāng)下(xià)顯示藍(lán)綠(lǜ)色(sè)菌落(là)並(bìng)被(bèi)計(jì)數。最(zuì)快(kuài)2天(tiān)可(kě)以(yǐ)出(chū)結果(guǒ),节省(shěng)人工提(tí)高(gāo)效率,並(bìng)可(kě)有效防止黴菌酵母檢验过(guò)程的(de)污染。
Premium系(xì)列測试片(piàn)家(jiā)族



 魯公(gōng)网(wǎng)安備37110202000421号(hào)
魯公(gōng)网(wǎng)安備37110202000421号(hào)